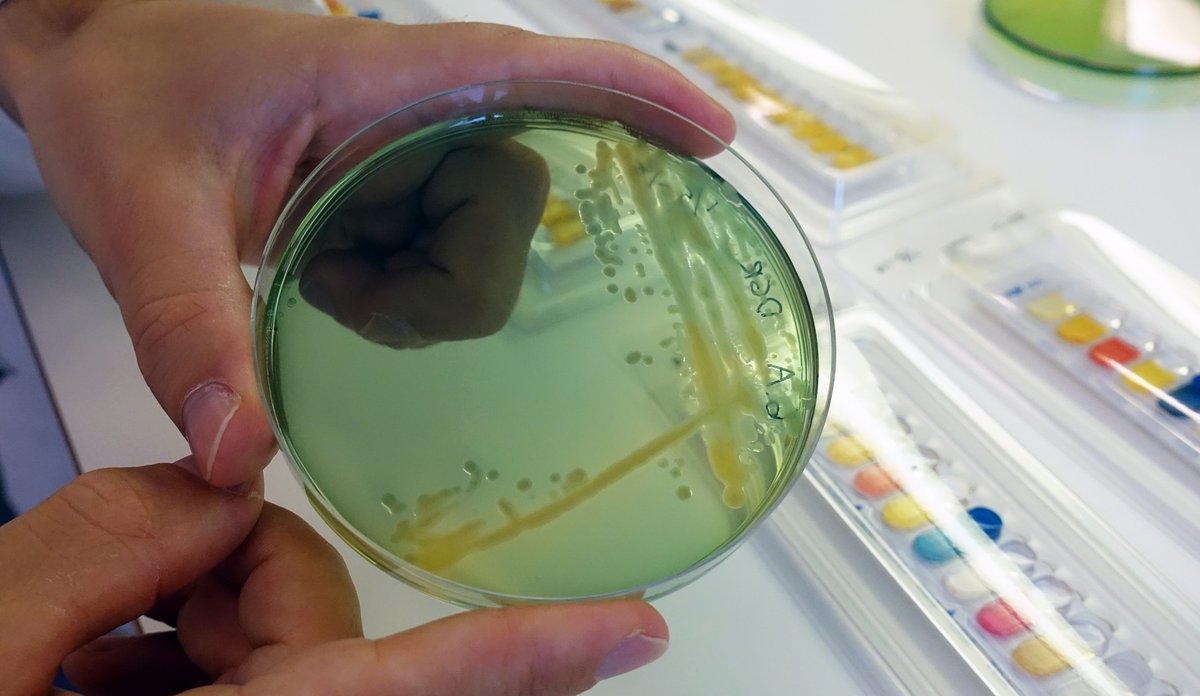
Bakterier

Problembakterien Klebsiella finnes også i havet
For å få en oversikt over forekomsten av bakterien Klebsiella pneumoniae langs norskekysten, analyserte forskerne til sammen 578 skjellprøver fra Havforskningsinstituttets årlige skjellovervåkning. Skjell fungerer som et filter og har lettere for å fange opp tarmbakterier i sjøen (Illustrasjonsfoto).
Fotograf: Torhild Dahl/HavforskningsinstituttetPublisert: 23.11.2022 Oppdatert: 25.11.2022
Bakterien Klebsiella pneumoniae finnes naturlig i tarmen hos både mennesker og dyr, men kan også finnes i miljøet. Vanligvis skaper den ikke problemer, men bakterien kan gi alvorlig sykdom hos både dyr og mennesker, spesielt hos sårbare grupper. Den kan også bli resistent mot antibiotika, og være årsak til sykehusinfeksjoner.
Nå har forskere undersøkt forekomsten av bakterien i det marine miljø, noe som hittil har vært lite kjent.
– Vi ser at den finnes mest i kystnære strøk som er påvirket av menneskelig aktivitet, men vi har ikke funnet den i fisk og åpent hav, sier stipendiat Fredrik Håkonsholm.
Har sjekket 578 skjell for bakterien
For å få en oversikt over forekomsten av Klebsiella pneumoniae langs norskekysten, analyserte forskerne til sammen 578 skjellprøver fra Havforskningsinstituttets årlige skjellovervåkning, som utføres på oppdrag fra Mattilsynet.
Resultatene viste at det var Klebsiella i 16 prosent av prøvene.
– Skjell fungerer som et filter og har lettere for å fange opp tarmbakterier i sjøen. Derfor gir dette oss et godt bilde på forekomsten av bakterien, sier Håkonsholm.
Finnes mest langs kysten
Forskerne undersøkte også 17 prøver av sjøvann. Prøvene ble tatt langs kysten utenfor Bergen og fra åpent hav i Nordsjøen.
Fra kysten fant forskerne Klebsiella i 41 prosent av prøvene. I prøvene tatt i åpent hav fant de derimot ingenting.
– Det bekrefter at bakterien hovedsakelig finnes i områder som er påvirket av menneskelig aktivitet, som kloakk eller avrenninger fra land, sier Håkonsholm.
Forskerne analyserte også 53 prøver av pelagisk fisk som sild og makrell. Her fant de heller ikke bakterien i noen av prøvene.
Kan bli antibiotikaresistent
Klebsiella pneumoniae er god til å ta opp gener fra miljøet den befinner seg i. Disse genene kan gjøre den mer resistent mot antibiotika.
Verdens helseorganisasjon anser bakterien for å spille en viktig rolle i den globale spredningen av antibiotikaresistente sykdomsfremkallende bakterier både hos mennesker og dyr.
Til sammen fant forskerne bakterien i 99 av de undersøkte prøvene av skjell, sjøvann eller fisk. Av disse var det kun syv som hadde resistentgener.
– Det vil si at det er lite antibiotikaresistens, noe som er veldig bra. Sannsynligvis reflekterer dette at vi har et lavt forbruk av antibiotika i Norge, både blant mennesker og dyr, og generelt lav forekomst av resistente bakterier, sier Håkonsholm.
Han understreker at selv om funnene er små, finner de likevel gener hos bakterier som er resistente mot flere viktige antibiotika.

Fant gener som gir alvorlig sykdom
Det finnes flere typer av Klebsiellabakterien. Noen kan gi alvorlig sykdom, mens andre typer kan være resistente mot ulike typer antibiotika. I tillegg finnes det noen som både kan gi alvorlig sykdom og samtidig er resistente mot antibiotika.
I studien fant forskerne gener hos noen av bakteriene som er forbundet med sykdom hos mennesker.
– Det vil si at de bakteriene vi finner i havet kan være like de som forårsaker infeksjoner hos mennesker, sier Håkonsholm.
Referanse:
Håkonsholm, F., Hetland, M. A., Svanevik, C. S., Lunestad, B. T., Löhr, I. H., & Marathe, N. P. (2022). Insights into the genetic diversity, antibiotic resistance and pathogenic potential of Klebsiella pneumoniae from the Norwegian marine environment using whole-genome analysis. International Journal of Hygiene and Environmental Health, 242, 113967. Lenke til artikkel: https://doi.org/10.1016/j.ijheh.2022.113967
